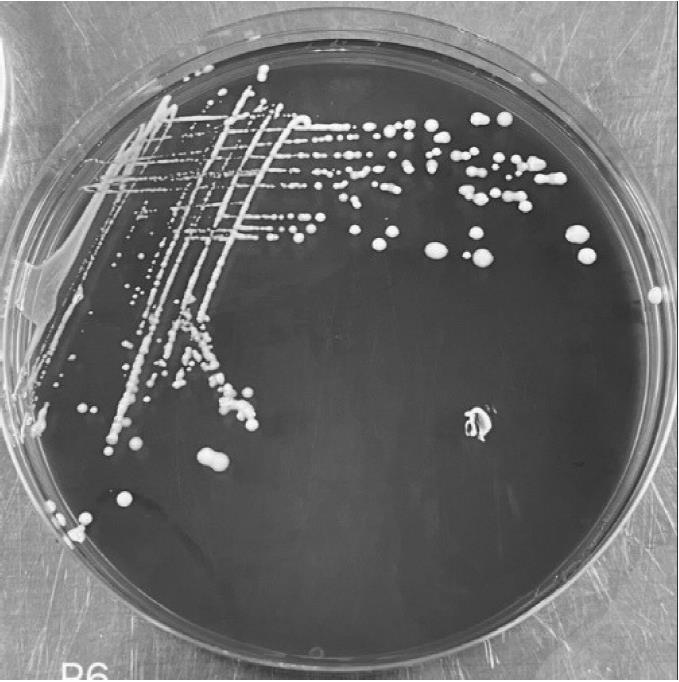

授权公布号:CN117431189B
一株副干酪乳杆菌副干酪亚种菌株QH-20029及其应用
有效
申请
2023-12-08
申请公布
2024-01-23
授权
2024-03-15
预估到期
2043-12-08
| 申请号 | CN202311674596.9 |
| 申请日 | 2023-12-08 |
| 申请公布号 | CN117431189A |
| 申请公布日 | 2024-01-23 |
| 授权公布号 | CN117431189B |
| 授权公告日 | 2024-03-15 |
| 分类号 | C12N1/20;C12J1/04;C12R1/225N |
| 分类 | 生物化学;啤酒;烈性酒;果汁酒;醋;微生物学;酶学;突变或遗传工程; |
| 申请人名称 | 千禾味业食品股份有限公司 |
| 申请人地址 | 四川省眉山市东坡区城南岷家渡 |
专利法律状态
2024-03-15
授权
状态信息
授权
2024-02-09
实质审查的生效
状态信息
实质审查的生效;IPC(主分类):C12N1/20;专利申请号:2023116745969;申请日:20231208
2024-01-23
公布
状态信息
公布
摘要
本发明涉及微生物技术领域,具体公开了一株副干酪乳杆菌副干酪亚种菌株QH‑20029及其应用,副干酪乳杆菌副干酪亚种(Lactobacillus paracasei subsp.paracasei)菌株保藏于中国微生物菌种保藏管理委员会普通微生物中心,其保藏名称为QH‑20029,保藏编号为CGMCC No.24916。本发明所述副干酪乳杆菌副干酪亚种菌株QH‑20029能在酸性条件下及高乙醇条件下生长代谢并产酸,具有高产乳酸、琥珀酸的能力,并能降低生物胺,特别是组胺。将其运用于食醋酿造中,可显著提高食醋酿造原料出醋率,提升食醋中不挥发酸含量特别是乳酸与琥珀酸含量,并能显著降低食醋生物胺含量,提高食醋产品品质。